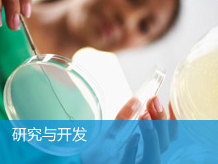

Innovation
|
Contact Us |
Site Map |
Legal|
Links |
RSS China National Bluestar (Group) Co,Ltd. all rights reserved. Without written authorization from China National BlueStar (Group) Co,Ltd. such content shall not be republished or used in any form. |